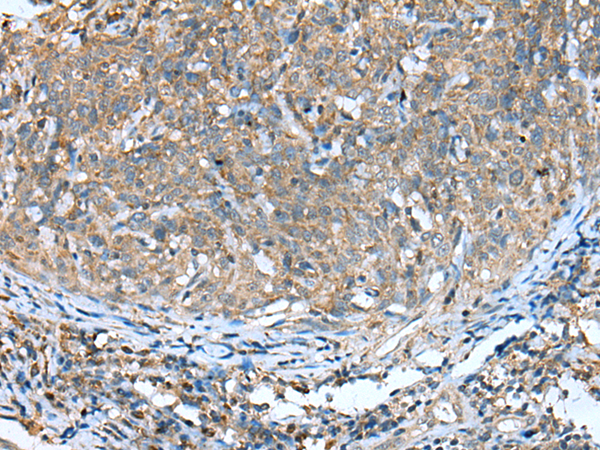

|
Background: |
The protein encoded by this gene acts as a homotetramer to catalyze diacetyl reductase and L-xylulose reductase reactions. The encoded protein may play a role in the uronate cycle of glucose metabolism and in the cellular osmoregulation in the proximal renal tubules. Defects in this gene are a cause of pentosuria. Two transcript variants encoding different isoforms have been found for this gene. |
|
Applications: |
ELISA, WB, IHC |
|
Name of antibody: |
DCXR |
|
Immunogen: |
Full length fusion protein |
|
Full name: |
dicarbonyl/L-xylulose reductase |
|
Synonyms: |
XR; DCR; HCR2; P34H; HCRII; KIDCR; PNTSU; SDR20C1 |
|
SwissProt: |
Q7Z4W1 |
|
ELISA Recommended dilution: |
5000-10000 |
|
IHC positive control: |
Human gastric cancer and human cervical cancer |
|
IHC Recommend dilution: |
20-100 |
|
WB Predicted band size: |
26 kDa |
|
WB Positive control: |
293T and TM4 cell, human fetal liver tissue |
|
WB Recommended dilution: |
200-1000 |

購物車
幫助
021-54845833/15800441009
